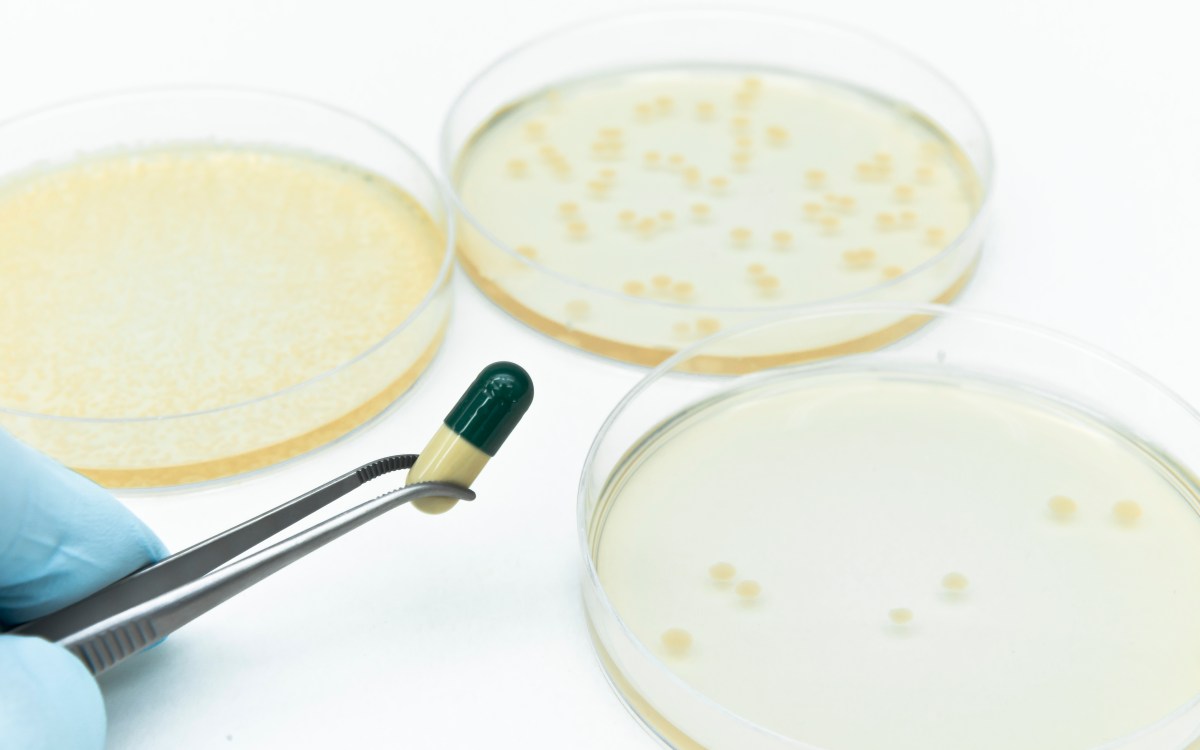

Urgent Matters
A series exploring how research is rising to major challenges in health and society
-
 Health
HealthMaking real gains in war on Alzheimer’s
Researchers hope new technologies, approaches usher in era of effective treatment for incurable disease amid urgency of ‘silver tsunami’
-
Health
HealthRacing against antibiotic resistance
Scientists fear funding cuts will slow momentum in ongoing battle with evolving bacteria


